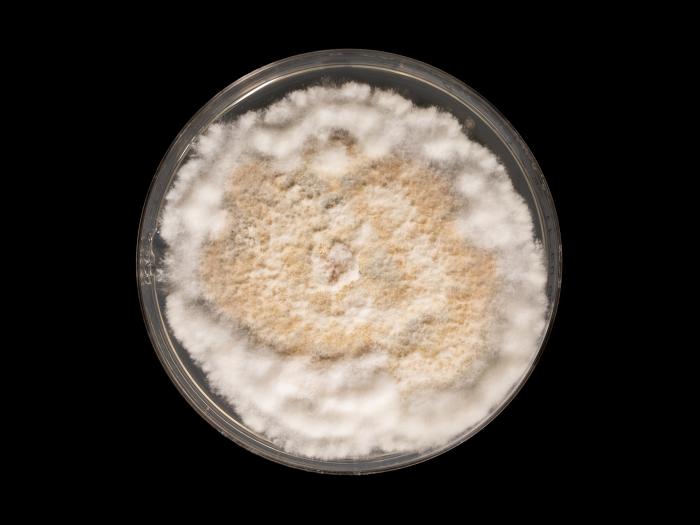
Neopestalotiopsis_sp_4

Identificateur
Mathilde Williatte-Battet
Crédit photo
Laboratoire d'expertise et de diagnostic en phytoprotection – MAPAQ
Fournisseur
Laboratoire de diagnostic en phytoprotection
Photographe
Mathilde Williatte-Battet
Légende
Neopestalotiopsis sur milieu SNA après 7 jours de croissance.
OrganisationFournisseur
MAPAQ - Direction de la phytoprotection (DP)